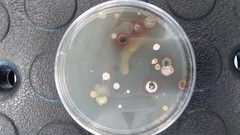
Streptomycetaceae
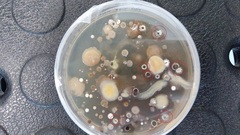
Streptomycetaceae

Streptomycetaceae: taxon details and analytics
- Domain
- Kingdom
- Bacteria
- Phylum
- Actinobacteria
- Class
- Order
- Actinomycetales
- Family
- Streptomycetaceae
- Genus
- Species
- Scientific Name
- Streptomycetaceae
Summary description from Wikipedia:
Streptomycetaceae
Streptomycetaceae is a family of the order Streptomycetales. It includes the important genus Streptomyces. This was the original source of many antibiotics, namely streptomycin, the first antibiotic against tuberculosis.
...Streptomycetaceae in languages:
- English
- streptomycetes
Parent Taxon
Sibling Taxa
- Actinomycetaceae
- Beutenbergiaceae
- Brevibacteriaceae
- Corynebacteriaceae
- Cryptosporangiaceae
- Dermacoccaceae
- Dermatophilaceae
- Frankiaceae
- Geodermatophilaceae
- Intrasporangiaceae
- Jiangellaceae
- Kineosporiaceae
- Microbacteriaceae
- Micrococcaceae
- Micromonosporaceae
- Mycobacteriaceae
- Nocardiaceae
- Nocardioidaceae
- Nocardiopsaceae
- Propionibacteriaceae
- Pseudonocardiaceae
- Sanguibacteraceae
- Sporichthyaceae
- Streptomycetaceae
- Streptosporangiaceae
- Thermomonosporaceae